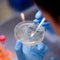
Anti-vaxxers spread fear about future coronavirus vaccine

Hence then, the article about anti vaxxers spread fear about future coronavirus vaccine was published today ( ) and is available on CBS News ( Middle East ) The editorial team at PressBee has edited and verified it, and it may have been modified, fully republished, or quoted. You can read and follow the updates of this news or article from its original source.
Read More Details
Finally We wish PressBee provided you with enough information of ( Anti-vaxxers spread fear about future coronavirus vaccine )
Last updated :
Also on site :
- TLC member Chilli donated to Trump campaign, records show
- Kim Novak says Sydney Sweeney is ‘totally wrong’ to play her because she ‘looks sexy all the time’
- ‘Consequences will follow’: Marco Rubio breaks down after Europe rejects him, and he wasn’t ready for a dose of reality